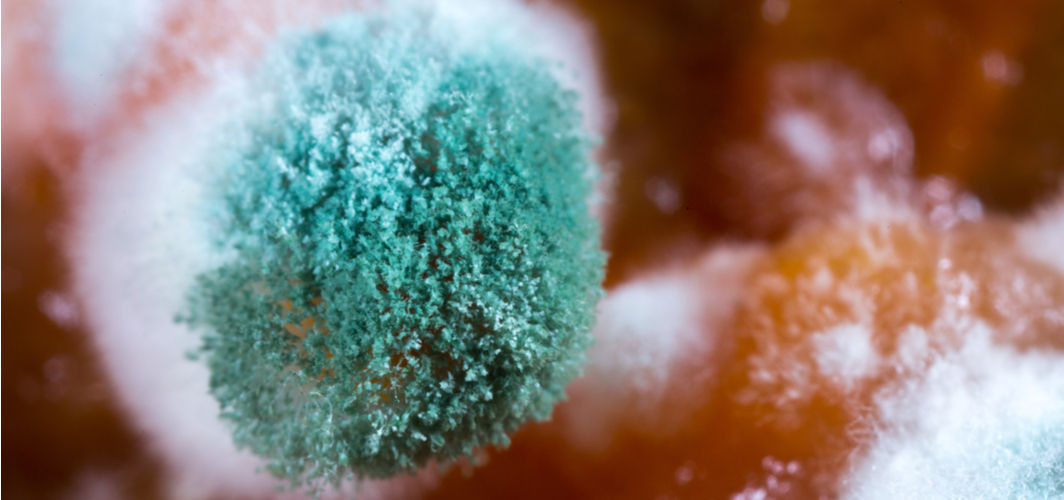
story-img

Coronavirus Updates
Post COVID-19 Recovery, Should You Get a Heart Check-up?
5 min read
By Apollo 24/7, Published on - 07 May 2021, Updated on - 18 October 2022
Share this article
2
21 likes

It is well known that the COVID-19 virus mainly targets the respiratory system, but increasing evidence indicates that it can also negatively affect other vital organs such as the heart, kidney and brain. While the recovery rate for most people suffering from COVID-infection is good, a few people may experience long-term health effects due to the infection. It has been reported that some people suffering from COVID-19 disease might suffer from heart damage even after they recover from the infection.
How does COVID-19 infection affect the heart?
Numerous studies conducted during the pandemic have shown that SARS-CoV-2, the virus that causes the COVID-19 disease, damages the heart by attaching itself to the ACE-2 receptors present on the blood vessels of the heart. Some of the ways in which the COVID-19 virus damages the heart include:
- Due to the increased release of cytokines and other inflammatory cells in response to the SARS-CoV-2 infection, the cells that help in the production of the heart muscles, myocytes, get damaged.
- Even in the absence of inflammation, the novel coronavirus damages the cardiac muscle (myocardium) and fibres, thereby hampering the heart’s ability to contract.
- Some people with even mild infection have developed myocarditis (inflammation of the heart muscles), which reduces the heart’s ability to pump blood.
- Due to increased viral infection and lack of oxygen to the heart tissues, there is extra pressure on the heart, which results in increased cardiac demand.
- The hearts of patients suffering from COVID-associated pneumonia or ARDS (acute respiratory distress syndrome) was found to experience hypoxia (lack of oxygen), which damages the myocardium.
Recommended Read: Can Coronavirus Have a Damaging Effect on the Heart?
Does the COVID-19 virus affect the patient’s heart after recovery?
In most cases, the damage caused by the COVID-19 virus to the heart or other vital organs is temporary. However, some studies have found that post COVID recovery, some patients may suffer from long-lasting heart damage. Various studies reported that post-COVID, cardiac problems were reported in previously healthy individuals too. Some of these studies include:
- In a recent study published in the journal Nature on 22nd April 2021, it was found that COVID-19 patients who developed severe symptoms during their disease period were at increased risk of suffering from heart diseases, kidney damage and diabetes, even 6 months’ post-recovery.
- A study published in the journal JAMA Cardiology examined the cardiac MRIs of 100 people who recovered from COVID in the past 2 to 3 months. The results of the study showed that 78% of the recovered patients had abnormalities in their heart, out of which 60% still had myocardial inflammation. The scientists further found that 76% of the patients had high levels of troponin in their blood, which is an enzyme that indicates heart damage. Most of these patients had mild symptoms of COVID-infection and did not require hospitalization.
- A study published in the European Heart Journal on 18th February 2021, examined the cardiac MRI of 148 COVID-recovered patients after 68 days of recovery. The results of the study showed that there was scarring of the heart in 39 patients due to inflammation and in 32 patients due to ischemic heart disease (death of heart tissue) and in 9 patients due to both reasons. Of these, 12 patients still had inflammation in their hearts.
What can be the signs of heart damage after recovering from the COVID-19 infection?
Some of the symptoms that may indicate heart damage after COVID recovery include:
- Rapidly increasing heartbeat
- Palpitations
- Extreme breathlessness
- Waking up at night due to shortness of breath
- Not being able to lie flat without feel breathless
- Swelling of ankles and feet
- Feeling lightheadedness or dizziness on standing
- Pain in the chest
- Brain fog
- Fatigue
The presence of any of these symptoms does not necessarily confirm a heart disease as they could also be the side effects of prolonged illness and inactivity. Proper tests need to be done by the doctor to confirm the diagnosis.
Recommended Read: What Tests Can Reveal Hidden Heart Problems?
How to take care of heart health post-COVID recovery?
After recovery from the COVID-19 infection, people must follow a healthy diet and adhere to medications as prescribed by their doctor. Meanwhile, a few tips that can keep the heart healthy after recovering from COVID-19 infection include:
- Consume a diet rich in protein and fibre, which is found in vegetables, fresh fruits, whole grains, legumes, nuts and seeds, eggs and soy.
- Avoid oily, processed and spicy foods.
- Check blood pressure frequently and report any significant fluctuations to the doctor.
- Get cholesterol levels checked every month.
- Practise moderate-intensity exercise such as brisk walking, cycling or swimming every day for 30 minutes to maintain a healthy weight.
- Quit smoking and limit alcohol consumption.
Recommended Read: Easy Cardio Exercises to Keep Your Heart Healthy
Takeaway
It is important to take care of one’s health post-recovery from COVID-infection. After consulting with a cardiologist, a recovered patient can get their heart scanned to examine any COVID-associated cardiac injury. If COVID-recovered people experience palpitations, breathlessness, swelling of legs or prolonged fatigue, they must contact their doctor for further assistance. While doctors believe that most of these injuries can heal on their own, some patients may require medications to accelerate the healing process.
Coronavirus Updates
Leave Comment
Recommended for you

Coronavirus Updates
COVID-19 Wave 2: What Are The New Symptoms?
The second wave of Coronavirus has hit India hard and is spreading fast. New strains of SARS-CoV-2 have been detected in this wave, which are causing symptomatic infections in patients.

Coronavirus Updates
How to Keep Yourself Physically Active During Lockdown
Regular physical activity can benefit both the body and mind, especially during the lockdown. It is also good for our mental health as it can reduce stress and enhance our overall mood.

Coronavirus Updates
Is Convalescent Plasma Therapy a Promising Treatment for COVID-19?
So far, there are no robust pieces of evidence to suggest that convalescent plasma therapy can be used as the definitive and sole treatment for COVID-19.
Subscribe
Sign up for our free Health Library Daily Newsletter
Get doctor-approved health tips, news, and more.
Visual Stories
Decoding India’s Fungal Epidemic Triggered by COVID-19
Tap to continue exploring
Recommended for you

Coronavirus Updates
COVID-19 Wave 2: What Are The New Symptoms?
The second wave of Coronavirus has hit India hard and is spreading fast. New strains of SARS-CoV-2 have been detected in this wave, which are causing symptomatic infections in patients.

Coronavirus Updates
How to Keep Yourself Physically Active During Lockdown
Regular physical activity can benefit both the body and mind, especially during the lockdown. It is also good for our mental health as it can reduce stress and enhance our overall mood.

Coronavirus Updates
Is Convalescent Plasma Therapy a Promising Treatment for COVID-19?
So far, there are no robust pieces of evidence to suggest that convalescent plasma therapy can be used as the definitive and sole treatment for COVID-19.